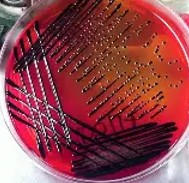

High Risk Samples
All staff are required by the Health and Safety at Work Act (1974) to take reasonable care for their own safety and that of other people who may be affected by their actions. Laboratory work is hazardous and extra precautions are necessary for certain specimens.
All specimens are potentially an infection risk and must be handled carefully. However, additional precautions are necessary for certain specimens from patients known or suspected to have infections that may be transmitted to laboratory and other health care workers.
Please mark such requests “Danger of Infection” in the clinical details or written on a manual request form. Lids of specimen containers must be securely tightened, and the containers securely sealed within the specimen bag attached to the request form.
Samples requiring labelling and handling as “Danger of Infection” / “Priority 10”
All specimens from patients suspected or proven to have the following infections:
- Stools from patients with suspected typhoid, paratyphoid or dysentery (e.g. recently returned from an endemic region such as the Indian sub-continent)
- Stool specimens from patients with suspected E. coli 0157 infection (haemolytic-uraemic syndrome (HUS)).
- Blood and urine cultures from patients with suspected typhoid or paratyphoid, or recently returned from an endemic region such as the Indian sub-continent.
- CSF, brain tissue and spinal cord material from patients at risk of or suspected of having a proven transmissible spongiform encephalopathy (CJD, vCJD etc.). Contact us | CJD (ed.ac.uk) Please liaise with Edinburgh reference laboratory to arrange a courier to collect the sample. Alert the Duty Microbiologist for your site between 9am – 5pm and ensure you make it clear on the request form that CJD testing is required.
- Covid/ MERS – samples must be double bagged. The outside bag must be marked as “Priority 10” so that the lab are alerted on arrival that it contains this.
- Upper respiratory tract specimens, blood cultures, CSF and samples from skin lesions from patients with suspected or proven meningococcal infection (until 24h after commencing antibiotic therapy).
- Other specimens as directed by the Infection Prevention and Control Team.
- All patients who have fever and have recently returned from an area where viral hemorrhagic fevers are endemic Ebola –Ebola virus disease: clinical management and guidance – GOV.UK (www.gov.uk). Specimens should NOT be collected from patients in whom a diagnosis of viral hemorrhagic fever is strongly suspected before consulting a Consultant Microbiologist.

